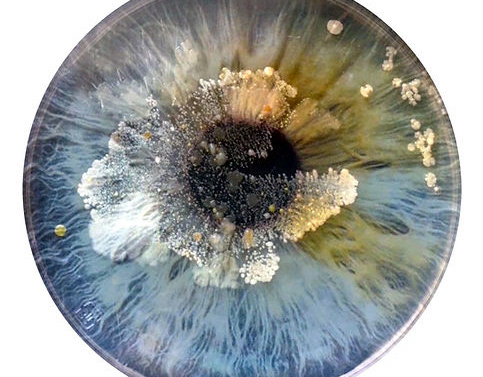

PASCUAL + VINCENT

JUAN CARLOS NADAL

CARLOS (NAOS) BELTRÁN CORRALIZA
Petrer, (Alicante), 1982

PALOMA NAVARES
Burgos, 1947. Vive y trabaja entre Madrid y Alicante.

AMELIA NAVARRO
Novelda

NATALIA PERMIAKOVA "NAVKA"
Kungur (Rusia)

ÁNGEL OCHANDO REQUENA

BEATRIZ OLIVA HUERTA

EMILIO OLIVARES BELTRAN

MONTSERRAT ORDÓÑEZ PANADES

REINALDO ORTEGA
Güines (La Habana), 1977

EVA MARÍA ORTIZ GIMÉNEZ

PEDRO ORTIZ OLIVAS
Albacete, 1951

REBECA ORTS
Alicante, 1981

MILA ORTUÑO

RAMÓN PALMERAL
Piedrabuena (Ciudad Real), 7 de mayo de 1947

NATIVIDAD PAMIES DIEZ

ALEJANDRO PASTOR (ALEXANDER GRAHOVSKY)
Alicante, 1980
ANNA PASTOR

ANTONIO PASTOR GEA
06 de noviembre de 1970

JAVIER PASTOR MILLET
Alicante, 1953

LUISA PASTOR
Alicante, 1977

MARI PAZ -PAU- PELLÍN SÁNCHEZ

MARÍA PERCEVAL GRAELLS
Elx, 1983

CHIMO PÉREZ MARÇÁ
Alicante, 1968.

JANA PERINGER

ELVIRA PIZANO ROVIRA
Albacete, 1935

JUAN ANTONIO POBLADOR
Madrid, 23/12/1951. Vive en Alicante

SANDRA PRIMO-COLBOURNE

SHARON KARINA PULIDO
Ramiriquì, Boyacá (Colombia)

VICENTE M. QUILES GUIJARRO
Alicante, 01 de enero de 1952

JUAN RIBES

NELLI RIHACEK

ADRIÁN RIPOLL GARCÍA

M. JESÚS RODRÍGUEZ MARÍN

ROGGER JUAREZ
Argentina, 1985.

RAFAEL RICOY OLARIAGA
Alicante, 1980

FRAN ROMERO BLANCO

MIGUEL ROMERO COLLADO

KIKII ROSE

CRISTINA RUERA

PILAR SALA VALLEJO

ALFONSO SÁNCHEZ

BEGOÑA SÁNCHEZ BUENO

CLARA SÁNCHEZ SALA
Alicante, 1987

FRANCISCO SÁNCHEZ SORIA
Torrevieja, 1952 afincado en Almoradí.

JESÚS LOZANO SAORÍN
Jumilla (Murcia) , 10 de julio de 1957. En Elche desde 1984

CATLIN SCHLOSSER BAUTISTA
Hungría, 1952

DIETMAR SCHMIDT

GLORIA SEGURA JORDÁ
Alcoi, 1979

JOSE ANTONIO SERNA RAMOS
Alicante, 1927 - Valencia, 2011

TERESA SILVESTRE

TOMÁS SIVERA VALLÉS
Jávea (Alicante), 1958

HANS SOME
Munich (Alemania), 1968

STEVE_XVIDA

JOSÉ SUCH
Alicante, 1979

SUNY FERNANDEZ ALCÁNTARA
15 de agosto de 1934

ELISA TERROBA
Arriate (Málaga), 1986

MITAR TERZIC
Herceg Novi (Montenegro), 1959

QUINO TORREGROSA
Denia

ANTONIO LÓPEZ URIOS

PACO VALVERDE
1964

BEA VERDÚ

SILVIA VIANA CHAVES
Fuenterrobles (Valencia), 1970. Vive y trabaja en Altea.

BERTA VICENTE MARTÍNEZ

JORGE VILLALBA STROHECKER
Alicante, 1975

INES VILLEPARISIS

JUACO VIZUETE
Alicante, 1972
LUIS ZARAGOZA